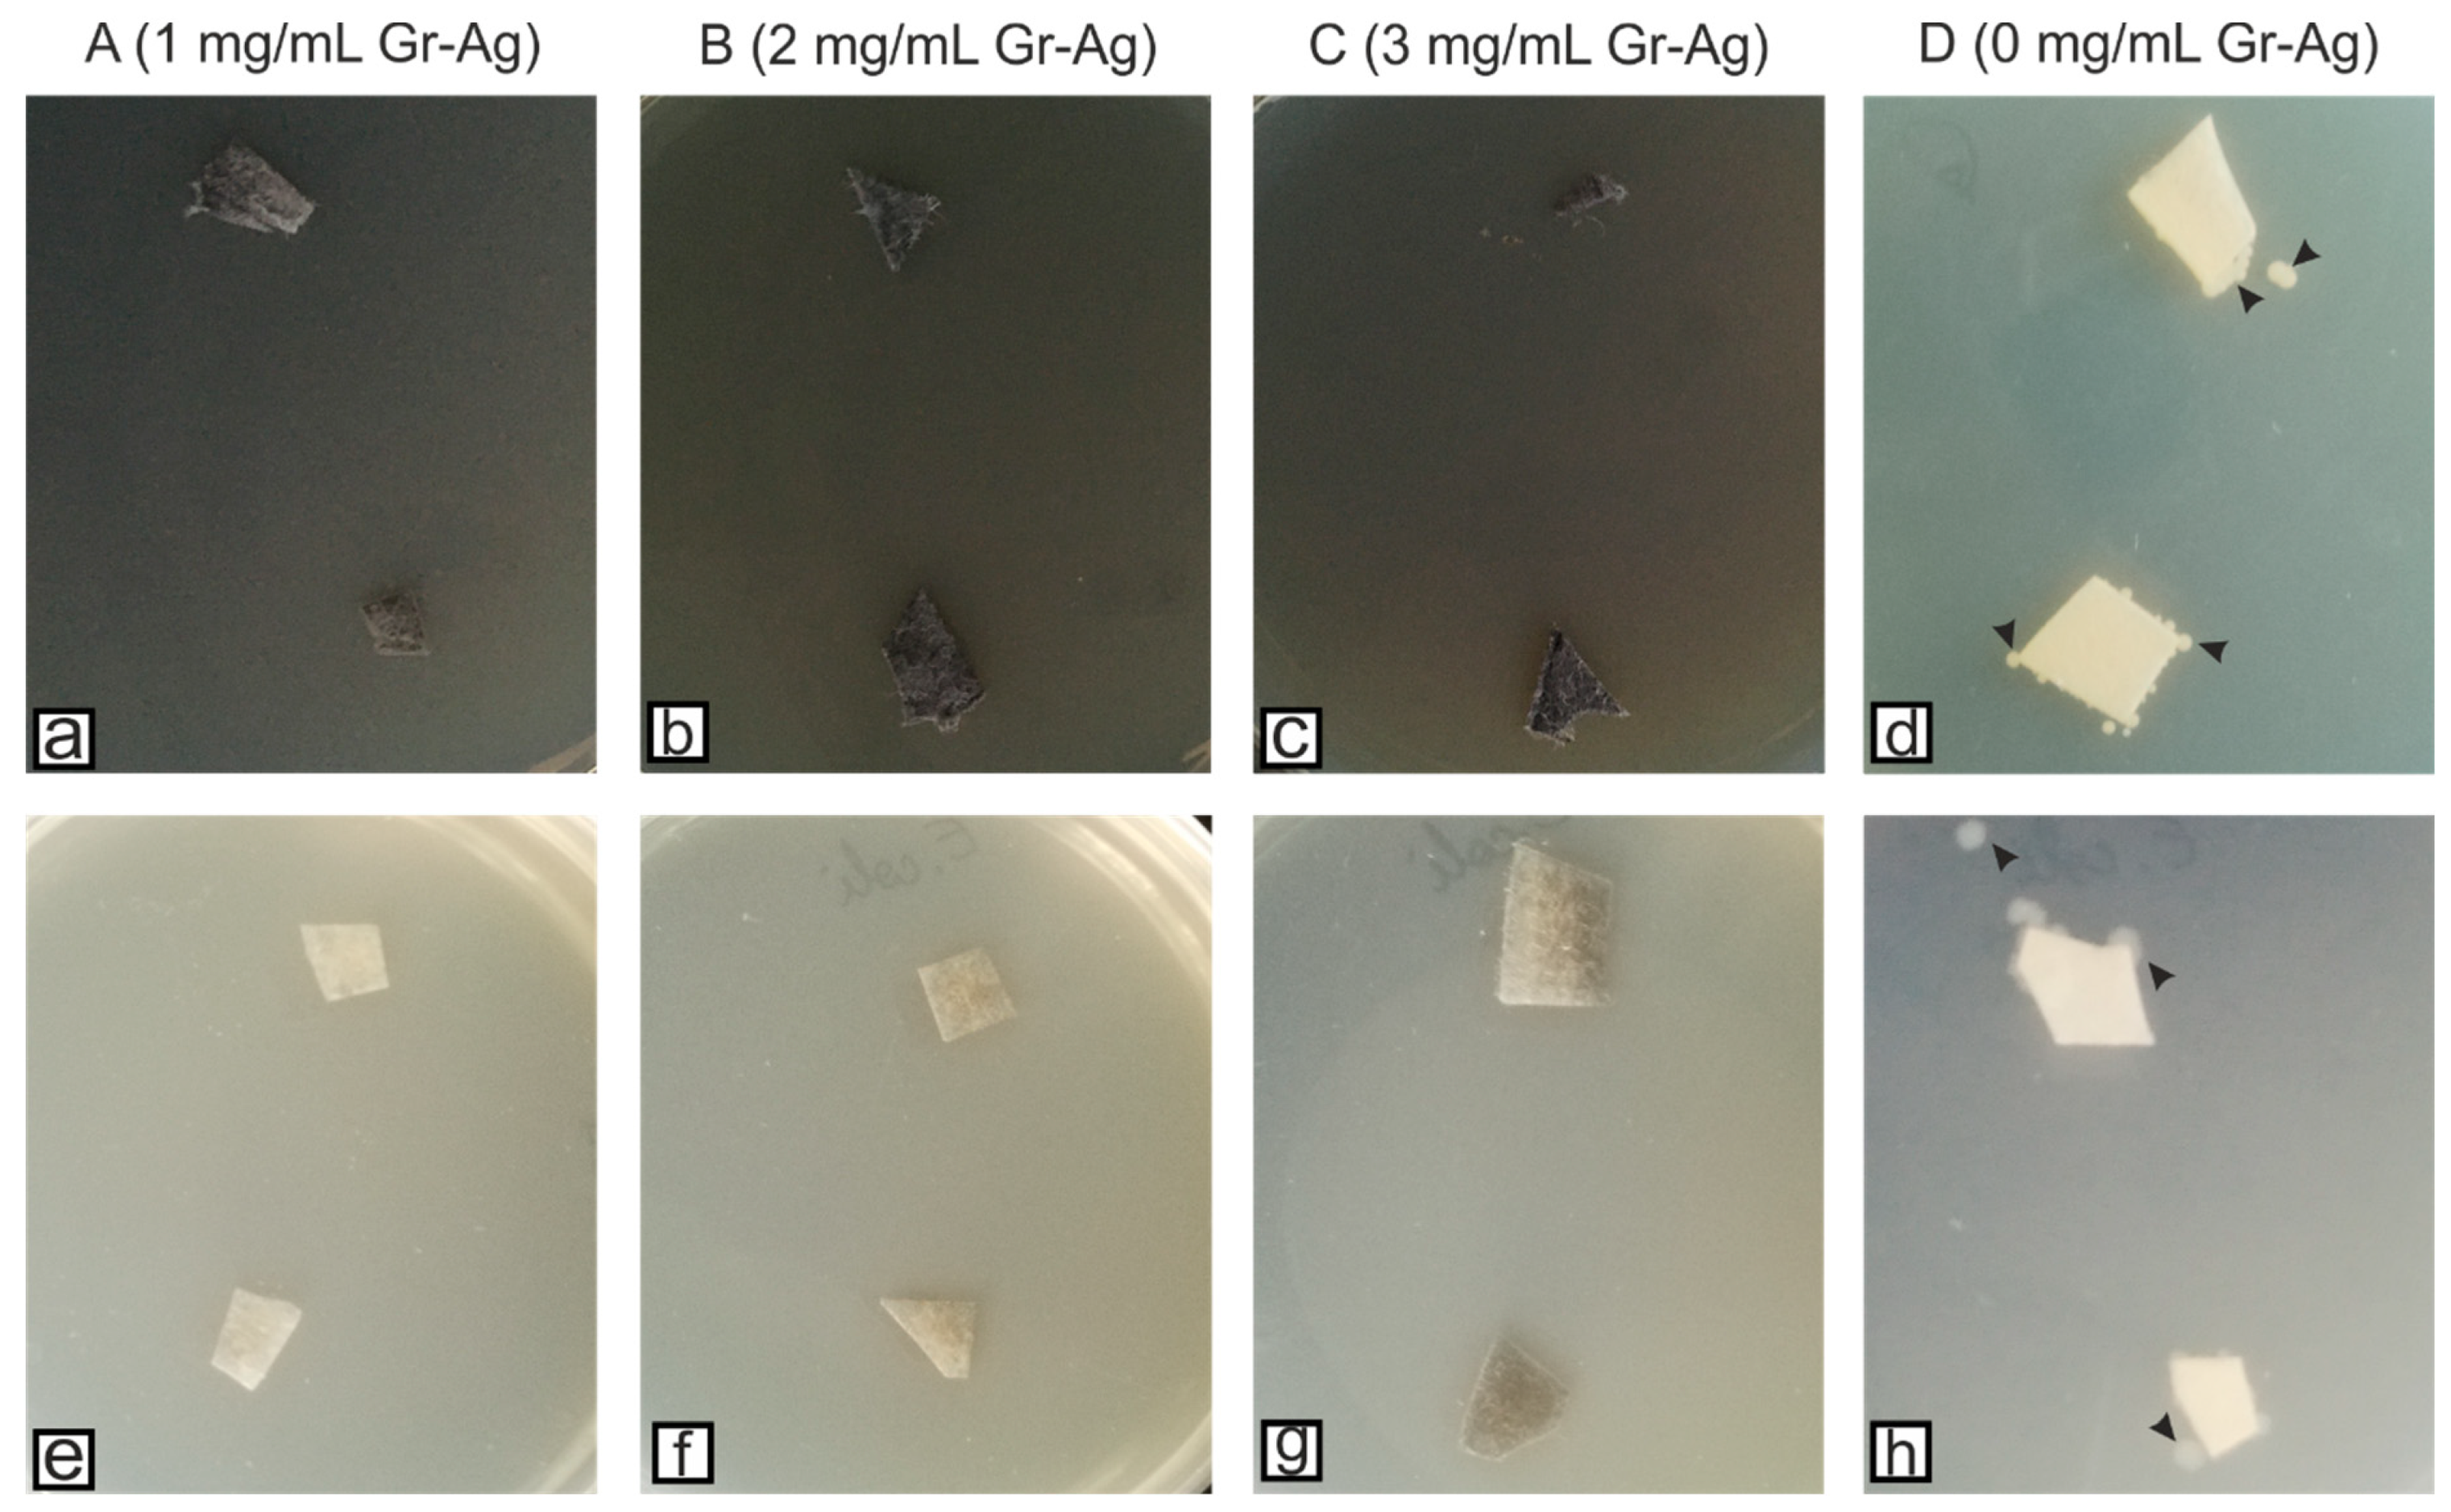
Microorganisms 11 00745 g004 Microorganisms 11 00745 g004
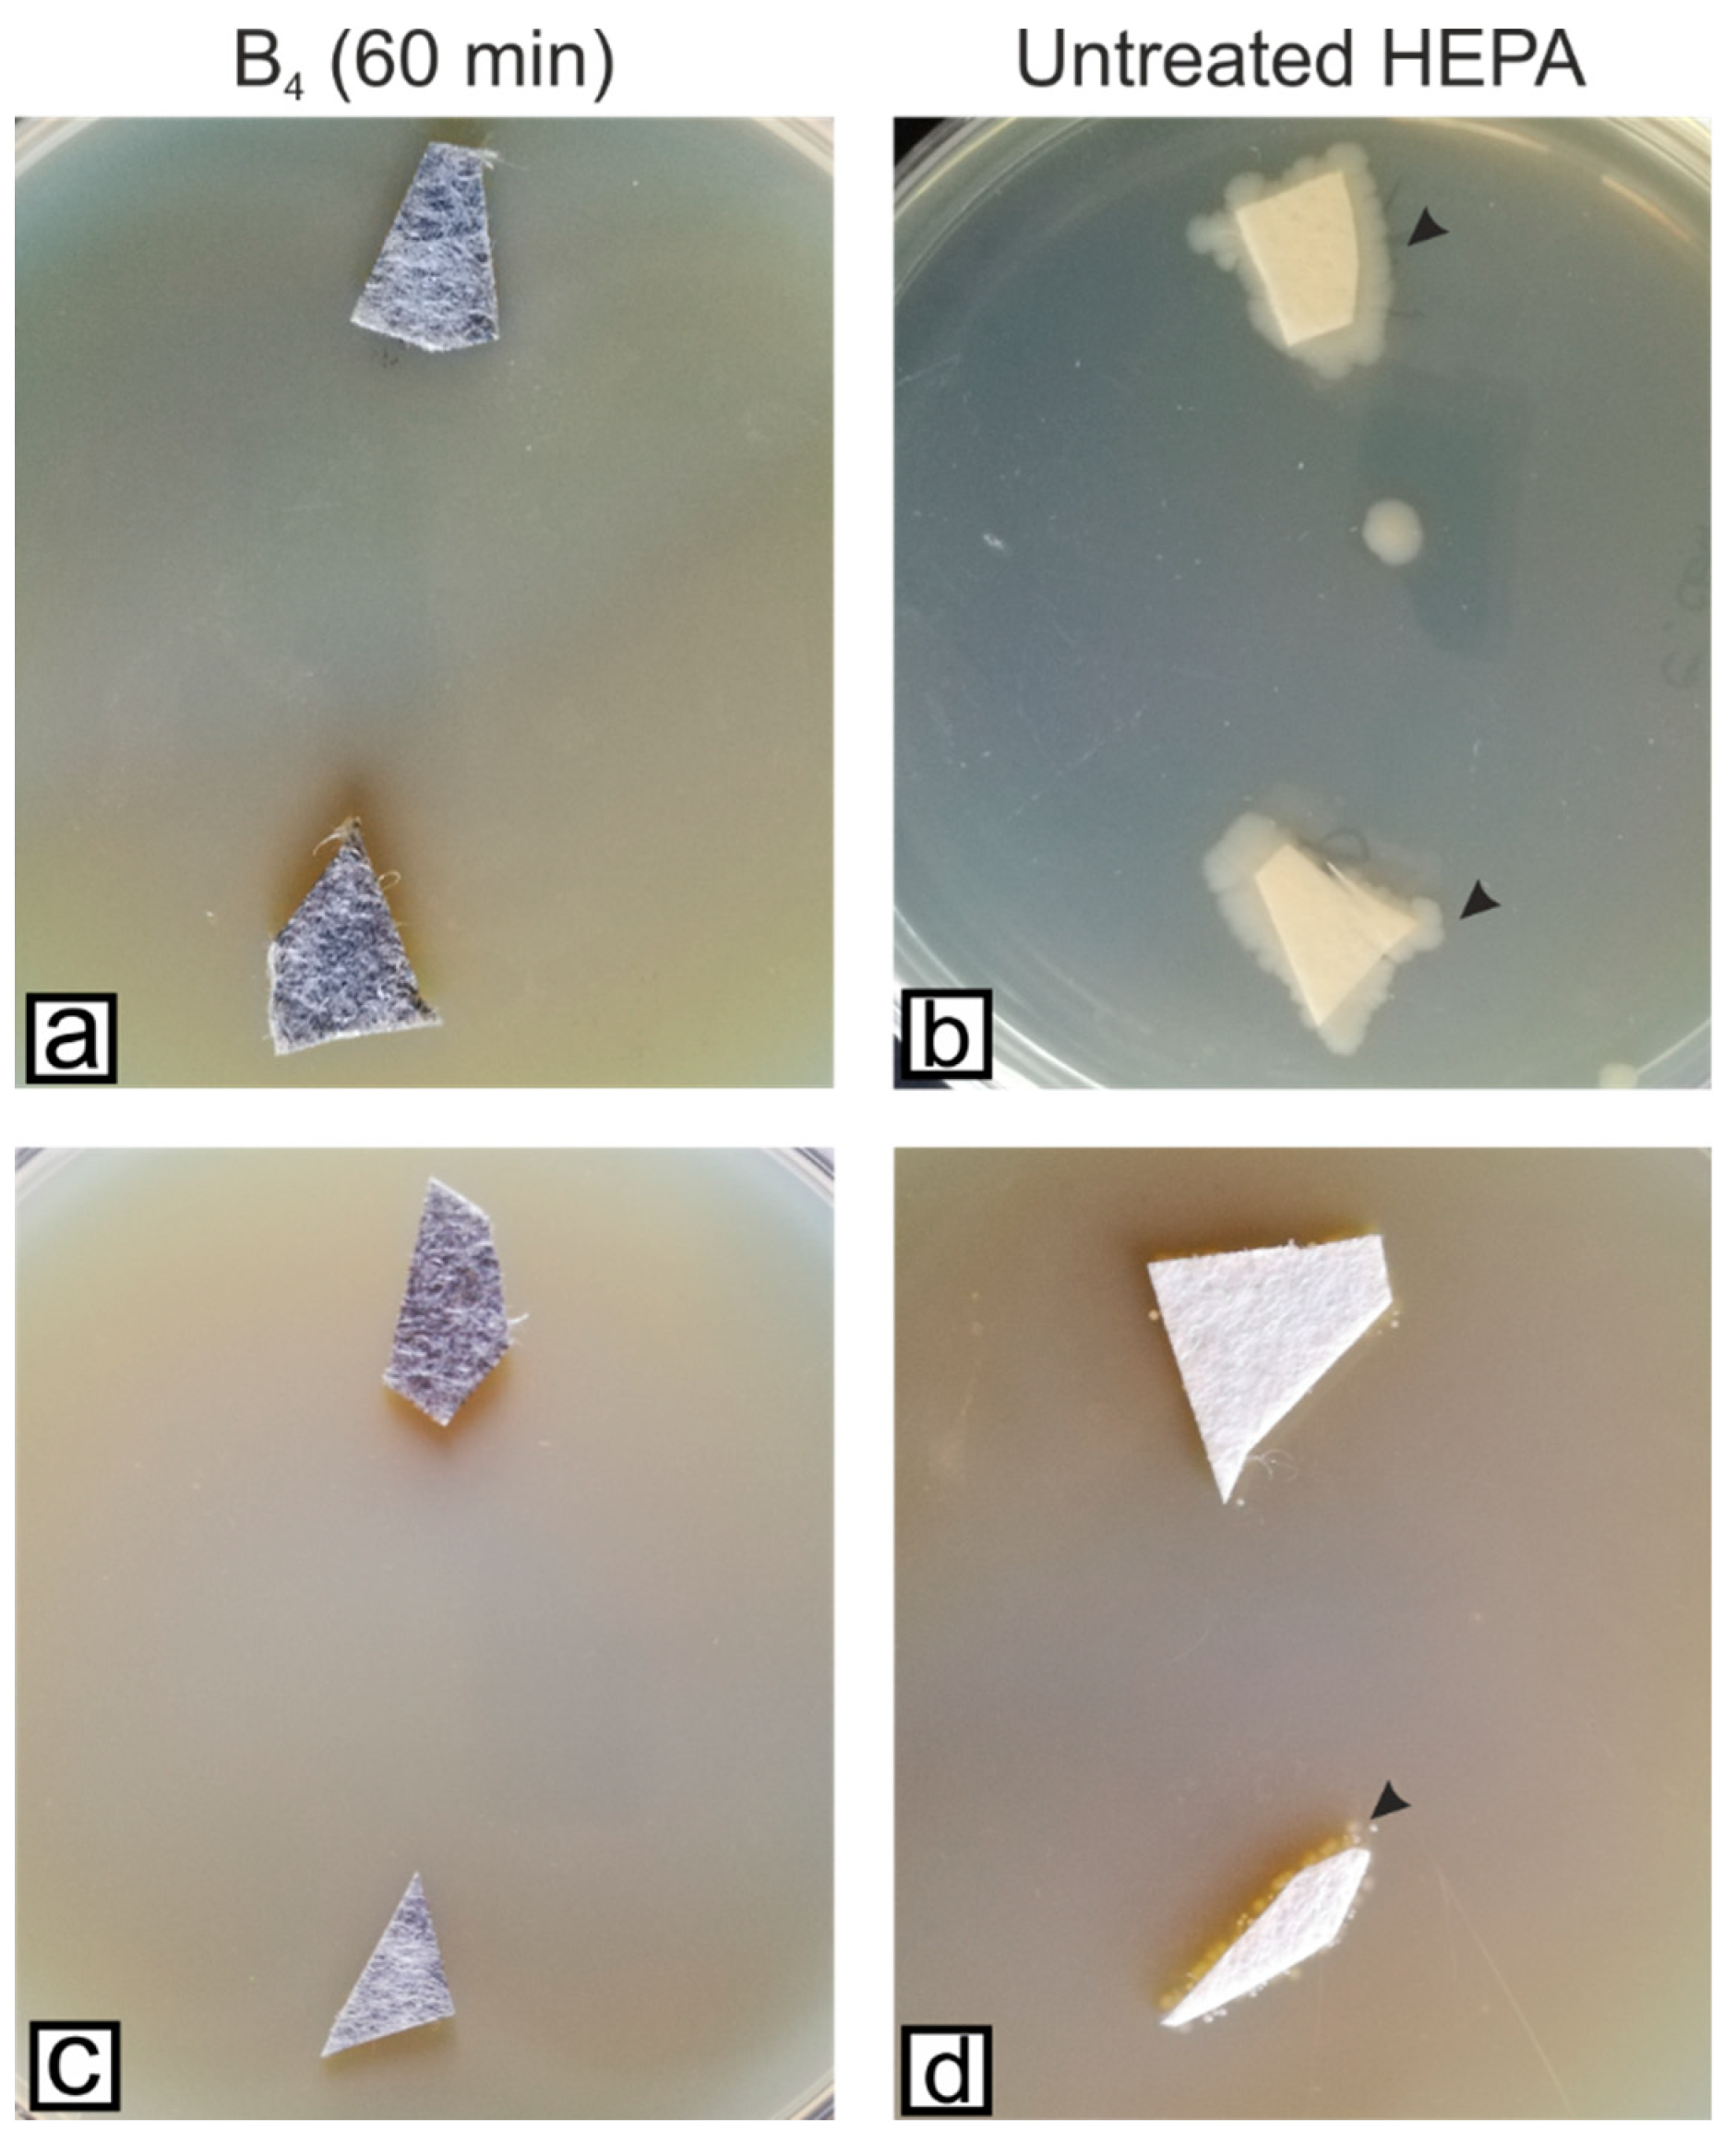
Microorganisms 11 00745 g007 Microorganisms 11 00745 g007

Antibacterial Enhancement of High-Efficiency Particulate Air Filters Modified with Graphene-Silver Hybrid Material
Abstract
1. Introduction
2. Materials and Methods
2.1. Chemicals
2.2. Apparatus
2.3. Synthesis of Reduced Graphene Oxide (rGO)
2.4. Synthesis of Gr-Ag (3, 5 and 20 wt% Ag) Hybrid Materials
2.5. Antibacterial Characterization of rGO, AgNPs, and Gr-Ag Hybrid Materials
2.6. Preparation of HEPA Filter Modified with Gr-Ag (5 wt% Ag) Hybrid Material
2.7. Microbiological Investigation of HEPA Filter Modified with Gr-Ag (5 wt% Ag) Hybrid Material
2.8. Statistical Analyses
3. Results
3.1. Antibacterial Activity of the Tested Materials (rGO, AgNPs, Gr-Ag)
3.2. Structural Characterization of Gr-Ag (5 wt% Ag) Hybrid Material
3.3. Microbiological Investigation of HEPA Filter Modified with Gr-Ag (5 wt% Ag) Hybrid Material
4. Discussion
5. Conclusions
Supplementary Materials
Author Contributions
Funding
Institutional Review Board Statement
Informed Consent Statement
Data Availability Statement
Acknowledgments
Conflicts of Interest
References
- D’Costa, V.M.; King, C.E.; Kalan, L.; Morar, M.; Sung, W.W.L.; Schwarz, C.; Froese, D.; Zazula, G.; Calmels, F.; Debruyne, R.; et al. Antibiotic resistance is ancient. Nature 2011, 477, 457–461. [Google Scholar] [CrossRef] [PubMed]
- Bakadia, B.M.; Lamboni, L.; Ahmed, A.A.Q.; Zheng, R.; Boni, B.O.O.; Shi, Z.; Song, S.; Souho, T.; Mukole, B.M.; Qi, F.; et al. Antibacterial silk sericin/poly (vinyl alcohol) hydrogel with antifungal property for potential infected large burn wound healing: Systemic evaluation. Smart Mater. Med. 2023, 4, 37–58. [Google Scholar] [CrossRef]
- Ciorîță, A.; Gutt, R.; Lung, I.; Soran, M.L.; Parvu, M. Green-synthesized Ag-MnO2 nanoparticles as plausible non-invasive antimicrobial treatment of cultural heritage. GeoPatterns 2021, 6, 6–10. [Google Scholar] [CrossRef]
- Huang, C.; Ye, Q.; Dong, J.; Li, L.; Wang, M.; Zhang, Y.; Zhang, Y.; Wang, X.; Wang, P.; Jiang, Q. Biofabrication of natural Au/bacterial cellulose hydrogel for bone tissue regeneration via in-situ fermentation. Smart Mater. Med. 2023, 4, 1–14. [Google Scholar] [CrossRef]
- Alavi, M.; Karimi, N. Characterization, antibacterial, total antioxidant, scavenging, reducing power and ion chelating activities of green synthesized silver, copper and titanium dioxide nanoparticles using Artemisia haussknechtii leaf extract. Artif. Cells Nanomed. Biotechnol. 2018, 46, 2066–2081. [Google Scholar] [CrossRef]
- Anandan, M.; Poorani, G.; Boomi, P.; Varunkumar, K.; Anand, K.; Chuturgoon, A.A.; Saravanan, M.; Prabu, H.G. Green synthesis of anisotropic silver nanoparticles from the aqueous leaf extract of Dodonaea viscosa with their antibacterial and anticancer activities. Process. Biochem. 2019, 80, 80–88. [Google Scholar] [CrossRef]
- Ganguly, R.; Singh, A.K.; Kumar, R.; Gupta, A.; Pandey, A.K.; Pandey, A.K. Nanoparticles as modulators of oxidative stress. Nanotechnol. Mod. Anim. Biotechnol. 2019, 2019, 29–35. [Google Scholar] [CrossRef]
- Dat, N.M.; Long, P.N.B.; Nhi, D.C.U.; Minh, N.N.; Duy, L.M.; Quan, L.N.; Nam, H.M.; Phong, M.T.; Hieu, N.H. Synthesis of silver/reduced graphene oxide for antibacterial activity and catalytic reduction of organic dyes. Synth. Met. 2020, 260, 116260. [Google Scholar] [CrossRef]
- Kuila, T.; Bose, S.; Mishra, A.K.; Khanra, P.; Kim, N.H.; Lee, J.H. Chemical functionalization of graphene and its applications. Prog. Mater. Sci. 2012, 57, 1061–1105. [Google Scholar] [CrossRef]
- Feng, L.; Liu, Z. Graphene in biomedicine: Opportunities and challenges. Nanomedicine 2011, 6, 317–324. [Google Scholar] [CrossRef]
- Mao, H.Y.; Laurent, S.; Chen, W.; Akhavan, O.; Imani, M.; Ashkarran, A.A.; Mahmoudi, M. Graphene: Promises, Facts, Opportunities, and Challenges in Nanomedicine. Chem. Rev. 2013, 113, 3407–3424. [Google Scholar] [CrossRef]
- Joshi, S.; Siddiqui, R.; Sharma, P.; Kumar, R.; Verma, G.; Saini, A. Green synthesis of peptide functionalized reduced graphene oxide (rGo) nano bioconjugate with enhanced antibacterial activity. Sci. Rep. 2020, 10, 9441. [Google Scholar] [CrossRef]
- Song, Y.; Wei, W.; Qu, X. Colorimetric Biosensing Using Smart Materials. Adv. Mater. 2011, 23, 4215–4236. [Google Scholar] [CrossRef] [PubMed]
- Izzaty, N.; Sastra, H.; Ilyas. The Implementation of Graphene Composites for Automotive: An Industrial Perspective. IOP Conf. Ser. Mater. Sci. Eng. 2019, 536, 012133. [Google Scholar] [CrossRef]
- Mahmoudi, T.; Wang, Y.; Hahn, Y.-B. Graphene and its derivatives for solar cells application. Nano Energy. 2018, 47, 51–65. [Google Scholar] [CrossRef]
- Allen, M.J.; Tung, V.C.; Kaner, R.B. Honeycomb Carbon: A Review of Graphene. Chem. Rev. 2010, 110, 132–145. [Google Scholar] [CrossRef]
- Wei, W.; Qu, X. Extraordinary Physical Properties of Functionalized Graphene. Small 2012, 8, 2138–2151. [Google Scholar] [CrossRef]
- Geim, A.K.; Novoselov, K.S. The rise of graphene. Nat. Mater. 2007, 6, 183–191. [Google Scholar] [CrossRef]
- Mei, L.; Zhu, S.; Yin, W.; Chen, C.; Nie, G.; Gu, Z.; Zhao, Y. Two-dimensional nanomaterials beyond graphene for antibacterial applications: Current progress and future perspectives. Theranostics 2020, 10, 757–781. [Google Scholar] [CrossRef]
- Du, J.; Tang, J.; Xu, S.; Ge, J.; Dong, Y.; Li, H.; Jin, M. A review on silver nanoparticles-induced ecotoxicity and the underlying toxicity mechanisms. Regul. Toxicol. Pharmacol. 2018, 98, 231–239. [Google Scholar] [CrossRef]
- Salaheldin, T.A.; El-Chaghaby, G.A.; El-Sherbiny, M.A. Green synthesis of silver nanoparticles using Portulacaria afra plant extract: Characterization and evaluation of its antibacterial, anticancer activities. Nov. Res. Microbiol. J. 2019, 3, 215–222. [Google Scholar] [CrossRef]
- Ahmad, A.; Wei, Y.; Syed, F.; Tahir, K.; Rehman, A.U.; Khan, A.; Ullah, S.; Yuan, Q. The effects of bacteria-nanoparticles interface on the antibacterial activity of green synthesized silver nanoparticles. Microb. Pathog. 2017, 102, 133–142. [Google Scholar] [CrossRef] [PubMed]
- Durán, N.; Durán, M.; de Jesus, M.B.; Seabra, A.B.; Fávaro, W.J.; Nakazato, G. Silver nanoparticles: A new view on mechanistic aspects on antimicrobial activity. Nanomedicine 2016, 12, 789–799. [Google Scholar] [CrossRef]
- Kunkalekar, R.K.; Prabhu, M.S.; Naik, M.M.; Salker, A.V. Silver-doped manganese dioxide and trioxide nanoparticles inhibit both Gram-positive and Gram-negative pathogenic bacteria. Colloids Surf. B Biointerfaces 2014, 113, 429–434. [Google Scholar] [CrossRef] [PubMed]
- Matharu, R.K.; Tabish, T.A.; Trakoolwilaiwan, T.; Mansfield, J.; Moger, J.; Wu, T.; Lourenco, C.; Chen, B.; Ciric, L.; Parkin, I.P.; et al. Microstructure and antibacterial efficacy of graphene oxide nanocomposite fibres. J. Colloid Interface Sci. 2020, 571, 239–252. [Google Scholar] [CrossRef] [PubMed]
- Gupta, K.; Bhattacharya, S.; Chattopadhyay, D.; Mukhopadhyay, A.; Biswas, H.; Dutta, J.; Ray, N.R.; Ghosh, U.C. Ceria associated manganese oxide nanoparticles: Synthesis, characterization and arsenic(V) sorption behavior. Chem. Eng. J. 2011, 172, 219–229. [Google Scholar] [CrossRef]
- Joubert, A.; Laborde, J.C.; Bouilloux, L.; Callé-Chazelet, S.; Thomas, D. Influence of humidity on clogging of flat and pleated HEPA filters. Aerosol Sci. Technol. 2010, 44, 1065–1076. [Google Scholar] [CrossRef]
- Coros, M.; Pogacean, F.; Turza, A.; Dan, M.; Berghian-Grosan, C.; Pana, I.-O.; Pruneanu, S. Green synthesis, characterization and potential application of reduced graphene oxide. Phys. E Low Dimens. Syst. Nanostruct. 2020, 119, 113971. [Google Scholar] [CrossRef]
- Pruneanu, S.; Biris, A.R.; Pogacean, F.; Socaci, C.; Coros, M.; Rosu, M.C.; Watanabe, F. The influence of uric and ascorbic acid on the electrochemical detection of dopamine using graphene-modified electrodes. Electrochimica Acta 2015, 154, 197–204. [Google Scholar] [CrossRef]
- Leclercq, R.; Cantón, R.; Brown, D.F.J.; Giske, C.G.; Heisig, P.; MacGowan, A.P.; Mouton, J.W.; Nordmann, P.; Rodloff, A.C.; Rossolini, G.M.; et al. EUCAST expert rules in antimicrobial susceptibility testing. Clin. Microbiol. Infect. 2013, 19, 141–160. [Google Scholar] [CrossRef]
- Lee, J.; Novoselov, K.S.; Shin, H.S. Interaction between metal and graphene: Dependence on the layer number of graphene. ACS Nano 2011, 5, 608–612. [Google Scholar] [CrossRef] [PubMed]
- Vi, T.; Kumar, S.; Pang, J.-H.; Liu, Y.-K.; Chen, D.; Lue, S. Synergistic antibacterial activity of silver-loaded graphene oxide towards Staphylococcus aureus and Escherichia coli. Nanomaterials 2020, 10, 366. [Google Scholar] [CrossRef] [PubMed]
- Menazea, A.A.; Ahmed, M.K. Synthesis and antibacterial activity of graphene oxide decorated by silver and copper oxide nanoparticles. J. Mol. Struct. 2020, 1218, 128536. [Google Scholar] [CrossRef]
- Prasad, K.; Lekshmi, G.S.; Ostrikov, K.; Lussini, V.; Blinco, J.; Mohandas, M.; Vasilev, K.; Bottle, S.; Bazaka, K.; Ostrikov, K. Synergic bactericidal effects of reduced graphene oxide and silver nanoparticles against Gram-positive and Gram-negative bacteria. Sci. Rep. 2017, 7, 1591. [Google Scholar] [CrossRef] [PubMed]
- Liu, H.; Liu, X.; Zhao, F.; Liu, Y.; Liu, L.; Wang, L.; Geng, C.; Huang, P. Preparation of a hydrophilic and antibacterial dual function ultrafiltration membrane with quaternized graphene oxide as a modifier. J. Colloid Interface Sci. 2020, 562, 182–192. [Google Scholar] [CrossRef]
- Truong, T.T.V.; Kumar, S.R.; Huang, Y.-T.; Chen, D.W.; Liu, Y.-K.; Lue, S.J. Size-dependent antibacterial activity of silver nanoparticle-loaded graphene oxide nanosheets. Nanomaterials 2020, 10, 1207. [Google Scholar] [CrossRef] [PubMed]
- Ahmad, N.; Nordin, N.A.H.M.; Jaafar, J.; Ismail, A.F.; Ramli, M.K.N.B. Significant improvement in antibacterial property of ZIF-8 decorated graphene oxide by post-synthetic modification process. J. Environ. Chem. Eng. 2021, 9, 105887. [Google Scholar] [CrossRef]
- Huo, S.; Gao, Y.; Fang, L.; Jiang, Z.; Xie, Q.; Meng, Q.; Fei, G.; Ding, S. Graphene oxide with acid-activated bacterial membrane anchoring for improving synergistic antibacterial performances. Appl. Surf. Sci. 2021, 551, 149444. [Google Scholar] [CrossRef]
- Liu, C.; Chen, F.-Y.; Tang, Y.-B.; Huo, P.-W. An environmentally friendly nanocomposite polypyrrole@silver/reduced graphene oxide with high catalytic activity for bacteria and antibiotics. J. Mater. Sci. Mater. Electron. 2021, 32, 15211–15225. [Google Scholar] [CrossRef]
- McNeilly, O.; Mann, R.; Hamidian, M.; Gunawan, C. Emerging Concern for Silver Nanoparticle Resistance in Acinetobacter baumannii and Other Bacteria. Front. Microbiol. 2021, 12, 652863. [Google Scholar] [CrossRef]
- Sengupta, I.; Bhattacharya, P.; Talukdar, M.; Neogi, S.; Pal, S.K.; Chakraborty, S. Bactericidal effect of graphene oxide and reduced graphene oxide: Influence of shape of bacteria. Colloid Interface Sci. Commun. 2019, 28, 60–68. [Google Scholar] [CrossRef]

| Materials | CFU/mL | |
|---|---|---|
| E. coli | S. aureus | |
| A | >1010 | 0 |
| B | 0 | 0 |
| C | 0 | 0 |
| D | >1010 | 6 × 1010 |
| Control | >1010 | 3 × 1010 |
| Materials | CFU/mL | |
|---|---|---|
| E. coli | S. aureus | |
| B1 | 0 | 0 |
| B2 | 0 | 0 |
| B3 | 0 | 0 |
| B4 | 0 | 0 |
| Untreated HEPA | >1010 | >1010 |
Disclaimer/Publisher’s Note: The statements, opinions and data contained in all publications are solely those of the individual author(s) and contributor(s) and not of MDPI and/or the editor(s). MDPI and/or the editor(s) disclaim responsibility for any injury to people or property resulting from any ideas, methods, instructions or products referred to in the content. |
© 2023 by the authors. Licensee MDPI, Basel, Switzerland. This article is an open access article distributed under the terms and conditions of the Creative Commons Attribution (CC BY) license (https://creativecommons.org/licenses/by/4.0/).
Share and Cite
Ciorîță, A.; Suciu, M.; Coroş, M.; Varodi, C.; Pogăcean, F.; Măgeruşan, L.; Mirel, V.; Ștefan-van Staden, R.-I.; Pruneanu, S. Antibacterial Enhancement of High-Efficiency Particulate Air Filters Modified with Graphene-Silver Hybrid Material. Microorganisms 2023, 11, 745. https://doi.org/10.3390/microorganisms11030745
Ciorîță A, Suciu M, Coroş M, Varodi C, Pogăcean F, Măgeruşan L, Mirel V, Ștefan-van Staden R-I, Pruneanu S. Antibacterial Enhancement of High-Efficiency Particulate Air Filters Modified with Graphene-Silver Hybrid Material. Microorganisms. 2023; 11(3):745. https://doi.org/10.3390/microorganisms11030745
Chicago/Turabian StyleCiorîță, Alexandra, Maria Suciu, Maria Coroş, Codruța Varodi, Florina Pogăcean, Lidia Măgeruşan, Valentin Mirel, Raluca-Ioana Ștefan-van Staden, and Stela Pruneanu. 2023. "Antibacterial Enhancement of High-Efficiency Particulate Air Filters Modified with Graphene-Silver Hybrid Material" Microorganisms 11, no. 3: 745. https://doi.org/10.3390/microorganisms11030745
APA StyleCiorîță, A., Suciu, M., Coroş, M., Varodi, C., Pogăcean, F., Măgeruşan, L., Mirel, V., Ștefan-van Staden, R.-I., & Pruneanu, S. (2023). Antibacterial Enhancement of High-Efficiency Particulate Air Filters Modified with Graphene-Silver Hybrid Material. Microorganisms, 11(3), 745. https://doi.org/10.3390/microorganisms11030745

